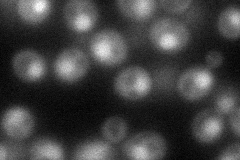

View description
Single-stranded DNA endonuclease (with Rad10p), cleaves single-stranded DNA during nucleotide excision repair and double-strand break repair; subunit of Nucleotide Excision Repair Factor 1 (NEF1); homolog of human XPF protein
Localization:
Intensity:
Fold change:
Significance:
-
C’ GFP library in SD

below threshold16.39 -
N' NOP1pr-GFP in SD
nucleus64.8637 -
N' TEF2pr-mCherry in SD

nucleus38.1273 -
N' NATIVEpr-GFP in SD

punctate,nucleus22.1881 -
N' TEF2pr-VC and Cyto-VN in SD

#N/A0 -
C’ GFP library in SD+DTT

cytosol13.330.81No -
C’ GFP library in SD+H2O2

cytosol17.951.09No -
C’ GFP library in Starvation Media

cytosol16.471No -
C’ GFP library on the background of Pup2-DaMP

below threshold -
C’ GFP library on the background of CCT mutant

below threshold18.04471.09974No
